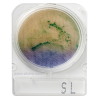
Test Kit E-Coli Coliform dan Salmonella | Microbiology Food and Water Test Kit

Alat uji bakteri E-Coli, Coliform dan Samonella, Test Kit E-Coli / Coliform, Test Kit Salmonella sangat cocok untuk pengawasan dan pengujian makanan dan minuman yang beredar, seperti jamuan makan para tamu VVIP, Jajanan anak sekolah, Pasar, Rumah sakit, Usaha katering dan pengujian makanan bagi anak sekolah (makan bergizi gratis - MBG)) agar terhindar dari bahaya penyakit yang diakibatkan dari bakteri, Jual test kit E-Coli, test kit Colifrom dan test kit Salmonella
 Security policy
Security policy
(edit with the Customer Reassurance module)
 Delivery policy
Delivery policy
(edit with the Customer Reassurance module)
 Return policy
Return policy
(edit with the Customer Reassurance module)
Microbiology Food and Water Test Kit
Type : ECOSAL-100
Fungsi : Alat Test Kit E-Coli / Coliform dan Salmonella pada sampel Makanan
Spesifikasi :
| Test Kit Uji Bakteri : | |||
| Uji bakteri siap pakai, sudah tersedia bantalan nutrisi pada cawan petri dish | |||
| 1 | Test Kit Uji E-Coli dan Coliform | : | 240 test |
| 2 | Test Kit Uji Salmonella | : | 240 test |
| 3 | Perlengkapan | ||
| ▪ | Tabung Penyaring Sampel Air, | : | 480 pcs |
| lengkap dengan filter 47mm, 0.45uM | |||
| ▪ | Spuit 100 ml | : | 6 pcs |
| ▪ | Aquades 500ml | : | 2 botol |
| ▪ | Plastik sampel (pack/100pcs) | : | 1 pack |
| Peralatan Pendukung | |||
| 1 | Cool Box (1 unit) | ||
| ▪ | Kapasitas | : | 20 Liter |
| ▪ | Ukuran | : | 47,2 cm x 27,1 cm x 30,2 cm |
| ▪ | Support | : | Selempang Jinjing |
| 2 | Blue Ice Pack (4 pcs) | ||
| ▪ | Ukuran | : | 22 x 15 x 3 cm |
| ▪ | Berat | : | Ice Pack: -/+800gr |
| 3 | Colony Counter | ||
| ▪ | Display | : | LCD 3 digits |
| ▪ | Lighting | : | Matrix LED (white light) |
| ▪ | Capacity of the Counter | : | 0-999 |
| ▪ | Diameter of the counting plate | : | Φ 115 mm |
| ▪ | Power consumption of lamp | : | 3-9 times |
| ▪ | Magnification | : | 16 W |
| ▪ | Total power consumption | : | <20 W |
| ▪ | Voltage | : | AC220V, 50/60Hz |
| ▪ | Volume | : | 225 x 210 x 160mm |
| ▪ | Weight | : | 2.2 kg |
| 4 | Portable Incubator | ||
| ▪ | Temperature range | : | +5 to 70°C |
| ▪ | Temperature Resolution ratio | : | 0,1 °C |
| ▪ | Temperature Control Mode | : | PID intelligent |
| ▪ | Capacity | : | 9,2 L |
| ▪ | Inner Chamber | : | Mirror stainless steel |
| ▪ | Outer shell | : | Cold rolling steel electrostatis |
| spraying exterior | |||
| ▪ | Insulation layer | : | Polyurethane |
| ▪ | Heater | : | Heating wire |
| ▪ | Timer | : | 0-9999 min |
| ▪ | Temp setting mode | : | Touch button setting |
| ▪ | Temp display mode | : | Measuring temp, LED upper row |
| ▪ | Shelf number | : | 4 |
| ▪ | Safety device | : | Over Temperature sound-light alarm |
| ▪ | Power | : | AC 220V (50/60hz) |
| ▪ | Size | : | 300 x 330 x 330cm (external) |
| : | 230 x 200 x 200 cm (inner chamber) | ||